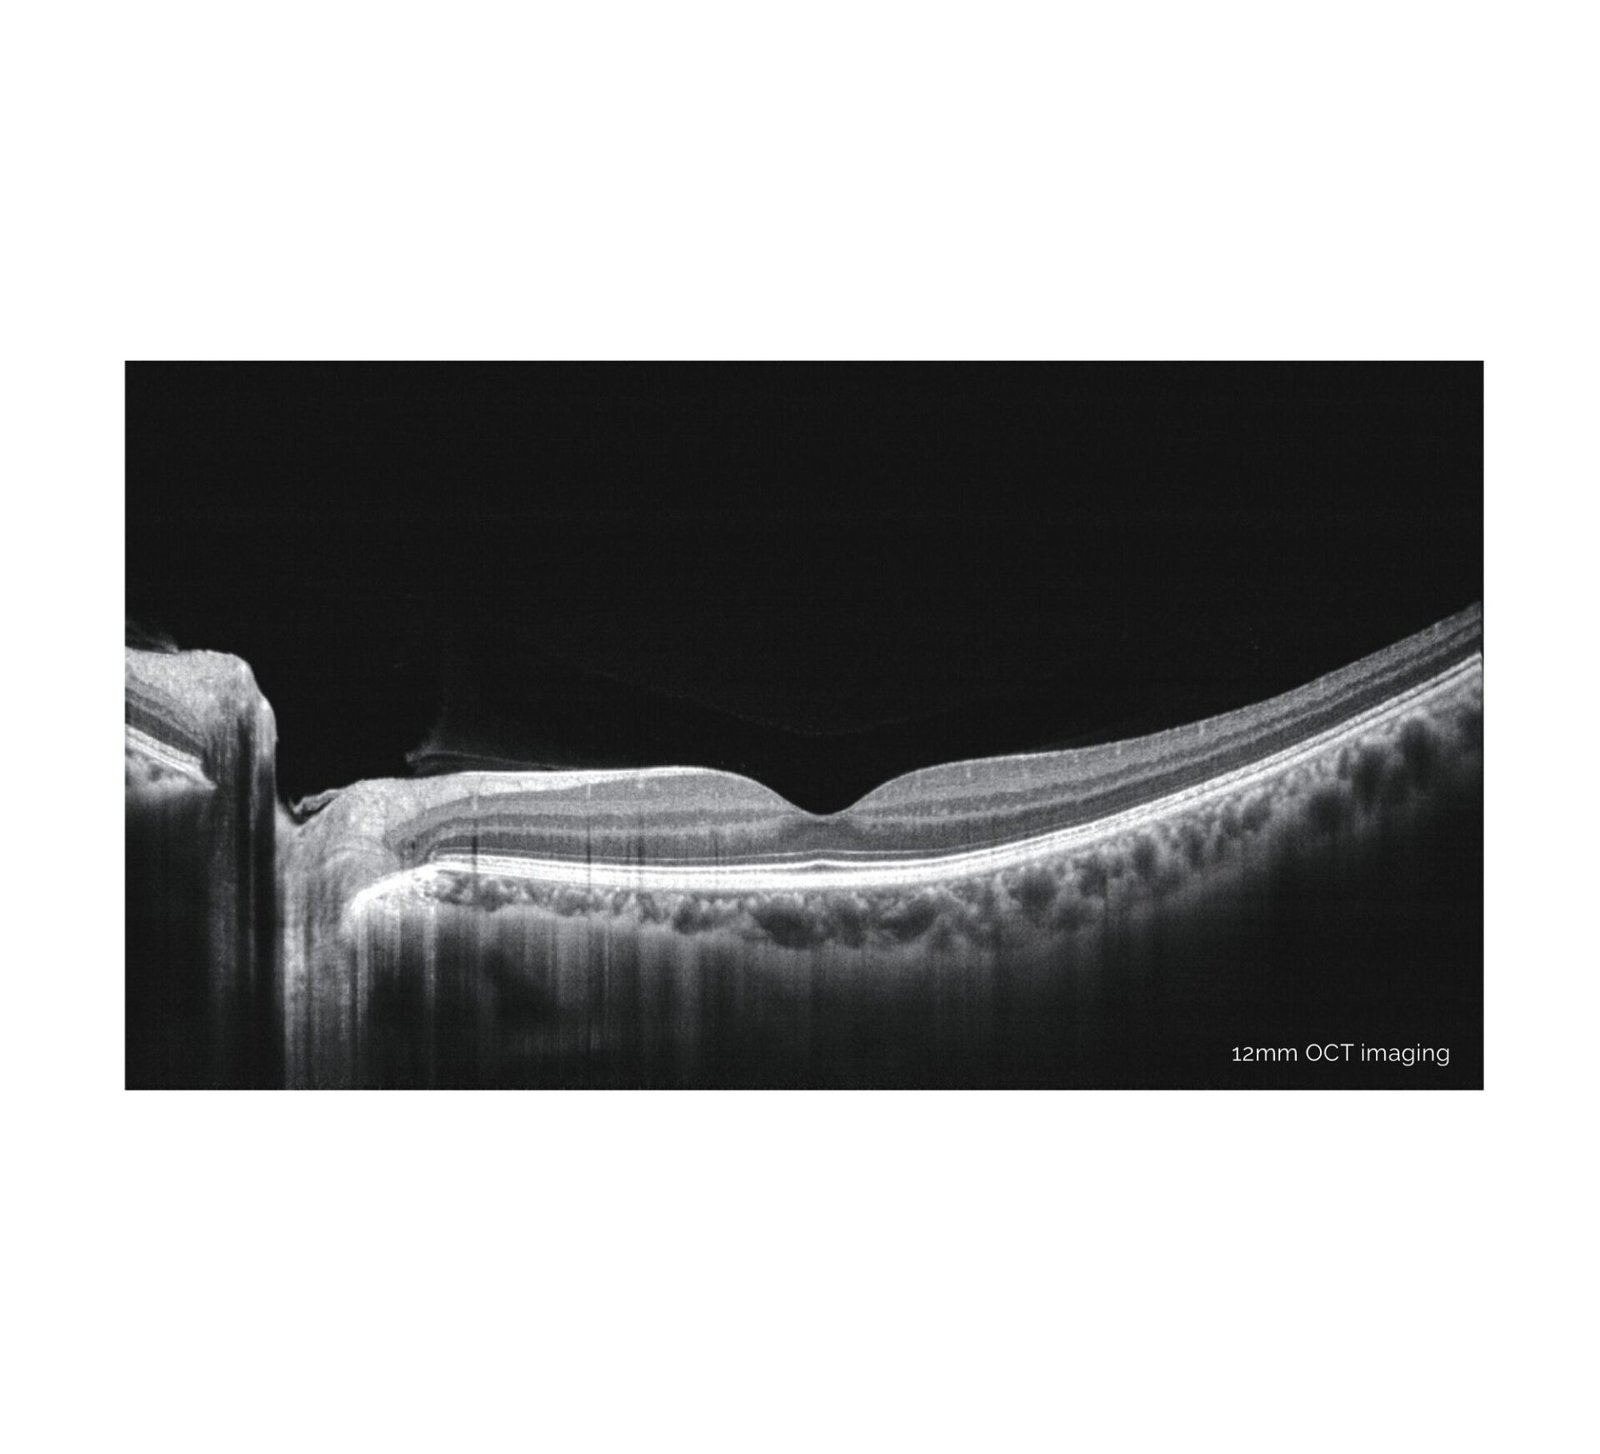

High Quality Real-Time SLO + Eye Tracking
Mocean® 3000 simultaneously acquires OCT images and 47 degrees fundus images based on Scanning Laser Ophthalmoscope (SLO), providing a real-time overview of the retina that allows easy localization of the lesion area before acquisition.
To minimize the artifacts caused by eye drift and micro saccades, Mocean® 3000 uses SLO-based eye tracker, which gives you more confidence in practice.
16mm Angle-To-Angle Analysis
16mm angle-to-angle anterior scan with data analysis.
Deep Choroidal Imaging (DCI) Mode
Using Deep Choroidal Imaging for detection of choroidal neovascularization.
Comprehensive Software Analysis And Free Upgrade
The Mocean® 3000 system provides 8 scan patterns to help you improve diagnostic efficiency:
Retina (HD line, Six-Radial lines, Multi, 3D Cube)
Glaucoma (Glaucoma Disc for ONH analysis, Glaucoma Macular for GCC analysis)
Cornea (HD line, Six-Radial lines, Angle-to-Angle)
The software analysis features are always up-to-date and free for upgrade (excluding OCTA module).